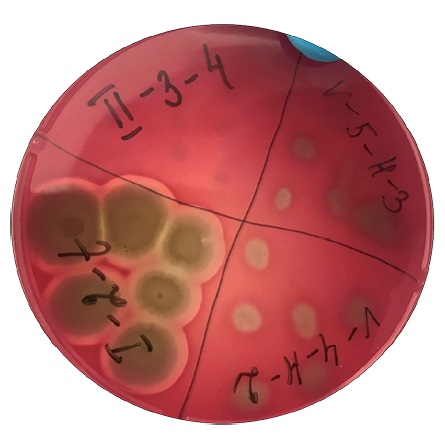
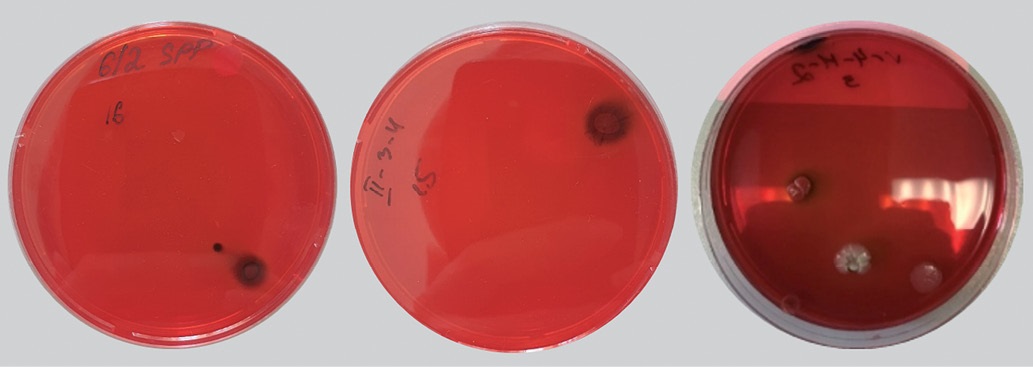

Scroll to:
Identification and some biological characteristics of Bacillus strains isolated from poultry large intestine
https://doi.org/10.29326/2304-196X-2025-14-3-302-309
Abstract
Introduction. Censuses of phylogenetic diversity of bacteria colonizing the intestinal tract of clinically healthy poultry conducted over the past decade indicate that up to 60% of genera present in the gut microbiome contain spore-forming bacteria, accounting for 30% of total gut microbiota. Benefits associated with using probiotics containing Bacillus spore-forming bacteria have been documented. Analysis of the prevalence of hemolytic and potential biofilm-forming activity, as well as antibiotic resistance in poultry gut spore-forming microbiota is essential for understanding the true role of aerobic spore-formers of the Bacillus genus in avian gut microbiome ecology.
Objective. Identification and investigation of biological characteristics (hemolytic activity, potential biofilm-forming capacity and antibiotic resistance) of Bacillus bacterial isolates obtained from the large intestine of poultry.
Materials and methods. Spore-forming bacteria were isolated from cecal content through sample heat treatment. Phenotypic identification was performed using API 50CHB biochemical test panels (bioMérieux, France). Hemolytic properties were assessed using Columbia agar (HiMedia Laboratories Pvt Ltd., India) supplemented with 5% sterile defibrinated sheep blood; catalase activity was assessed using 10% hydrogen peroxide according to General Pharmacopoeia Monograph GPM.1.7.2.0012.15; antibiotic sensitivity was assessed with disk diffusion test involving standard antibiotic-impregnated disks (5–30 μg/disk). Biofilm-producing, spore-forming bacteria were tested qualitatively using brain-heart infusion agar (BHI; HiMedia Laboratories Pvt Ltd., India) supplemented with Congo red and 5% sucrose.
Results. It was established that the cecal aerobic spore-forming microbiota in poultry comprised B. licheniformis, B. subtilis/amyloliquefaciens, B. mycoides, B. megaterium and B. cereus. All tested isolates were catalase-positive and lacked α-hemolytic activity. Some isolates demonstrated β-hemolytic activity. The overwhelming majority exhibited biofilm-forming phenotypes and showed susceptibility to tested antibiotics.
Conclusion. Vegetative forms of Bacillus spore-forming bacteria may potentially persist in or temporarily associate with the complex gut ecosystem. Hemolytically active intestinal isolates cannot be considered safe until the effects of this virulence factor on animals are clarified. These findings provide a basis for selecting candidate Bacillus strains for probiotic development.
For citations:
Malik N.I., Chupahina N.A., Rusanov I.A., Malik E.V., Malenkova L.A., Samokhvalova N.S., Surogin M.V. Identification and some biological characteristics of Bacillus strains isolated from poultry large intestine. Veterinary Science Today. 2025;14(3):302-309. https://doi.org/10.29326/2304-196X-2025-14-3-302-309
INTRODUCTION
The gut microbiota is crucial for maintaining host health by supplying essential nutrients, regulating energy balance, modulating immune responses and protecting against pathogens. Consequently, restoring and maintaining its stability with beneficial bacteria – rather than antibiotics – has been proposed as a strategy to prevent adverse effects on gut health [1].
A census of the phylogenetic diversity of bacteria identified in the intestinal tract of healthy poultry conducted over the past decade shows that up to 60% of the genera present in the gut microbiome contain spore-forming bacteria, and these genera account for 30% of the total gut microbiota [2][3].
In microbiome research, spore-forming bacteria are considered a distinct functional group within the broader microbiota. The term “sporobiota” has been proposed to describe the total collection of these bacteria in a given microbial community [4].
Endospores are formed by members of Firmicutes, a large, diverse and morphologically complex bacterial phylum [5]. Within it, species of the genus Bacillus (family Bacillaceae) have attracted the most scientific attention due to their significant role in modulating the intestinal microbiota [6].
While spore-forming bacteria of the genus Bacillus are primarily associated with the soil microbiome [7], their presence in the intestine is attributed to the consumption of feed and water. It has been conventionally assumed that Bacillus species enter the intestine exclusively in their spore form [8]. However, accumulating evidence suggests that some Bacillus species exhibit a bimodal life cycle, capable of both growth and sporulation not only in the environment but also within the gastrointestinal tract [9][10].
Spore-forming bacteria of the genus Bacillus are widely used in animal feed to promote animal growth and inhibit pathogens [11][12]. The probiotic mechanisms of these microorganisms involve synthesizing antimicrobial compounds and lactic acid [13], enhancing non-specific immunity [14], and producing enzymes such as amylase, lipase, protease, pectinase and cellulose [15]. Specifically, Bacillus subtilis stimulates growth of beneficial gut microbiota, increases intestinal microbiome diversity [16], modulates regulatory systems for intestinal epithelium renewal and immune cell activity [17], and mitigates the adverse effects of various factors, particularly antibiotic therapy [18][19].
It has also been shown that B. subtilis plays an important role in stimulating the development of gut-associated lymphoid tissue and that sporulation of live bacilli is considered critical for this process [20][21].
Survival and colonization within the digestive tract are essential for the microbiota to exert its physiological functions [22]. For spore-forming bacteria, a key prerequisite for intestinal colonization is the adhesion of spores to the intestinal mucosa and subsequent biofilm formation, a process that enables the transition of planktonic cells to attached forms [21][23].
The term “biofilm” is used to describe a structured community of bacterial cells embedded in a self-produced polymeric extracellular matrix and adhered to an inert or living surface [24]. This polymeric extracellular matrix is a complex system composed of exopolysaccharides, the TasA protein, lipids, nucleic acids and various heteropolymers, all of which are secreted by microorganisms into the extracellular environment [25]. Studies have shown that the TasA protein and exopolysaccharides are key components of the Bacillus biofilm matrix. TasA is an amyloid protein that has been implicated in the formation of the biofilm matrix by various microorganisms, including spore-forming bacteria [26][27][28][29].
Bacterial biofilms can protect bacteria from environmental stressors, host immune responses and antimicrobial agents, including antibiotics [30].
The use of Congo red dye to assess bacterial amyloid synthesis, and thus identify mucus or biofilm-forming organisms like Staphylococcus sp., was first proposed by D. J. Freeman et al. [31]. This method distinguishes biofilm-forming Staphylococcus colonies from non-forming ones based on their morphology and color on Congo red agar. Subsequent studies confirmed the utility of this assay for detecting potential biofilm formation in a broad spectrum of gram-positive and gram-negative microorganisms, including spore-forming bacteria of the genus Bacillus [32][33][34].
Recent data indicates that Bacillus sporulation is more active within biofilms than in planktonic cultures [35].
The growing threat of antibiotic-resistant pathobiont spread has brought to the forefront research focused on assessing the antibiotic resistance of the commensal gut microbiota as potential donors of resistance determinants.
In light of this problem, it has been suggested that spore-forming bacteria may play a significant role in the dissemination and accumulation of antibiotic resistance genes due to their ability to withstand antibiotic treatment [36][37]. However, the extent of antibiotic resistance and the biofilm-forming capacity among members of the intestinal sporobiota remain largely unknown.
Previous studies on the spread of antibiotic resistance and the biofilm-forming ability of Bacillus bacteria were focused on a limited number of species and did not include isolates derived from poultry gut microbiota [38][39][40][41].
The prevalence of hemolytic activity within the intestinal population of aerobic Bacillus bacteria remains insufficiently studied. Furthermore, the role of their hemolysins in maintaining intestinal mucosal integrity is unclear, and it has not been established that hemolysin production is harmless to the host. Non-hemolytic (γ-hemolytic) strains are generally considered safe for their hosts, while strains exhibiting hemolytic activity are deemed pathogenic [42][43].
Given the modern understanding of the gut microbiota’s role in maintaining gut colonization resistance, this knowledge gap leads to a lack of understanding regarding the true role of aerobic Bacillus spore-formers in the poultry gut microbiome and the specificity required for their selection and application as probiotics [44][45].
The relevance of this work is that the safety assessment of aerobic spore-forming Bacillus bacteria, which are widely used in the production of probiotic feed additives, is associated not only with species identification but also with the individual characteristics of the strains.
The novelty of the obtained data lies in the study of specific biological properties of isolates from the ceca of commercial poultry, thereby evaluating the prospects of using Bacillus bacteria for developing probiotic feed supplements.
The aim of this work is to investigate the biological properties of Bacillus isolates (hemolytic activity, potential for biofilm formation, and antibiotic resistance) obtained from the large intestine of poultry, with the goal of selecting promising strains for use in the biotechnology of probiotic production.
MATERIALS AND METHODS
Spore-forming bacteria used in this study were isolated from samples of the cecal content of clinically healthy poultry obtained from farms in the Moscow Oblast that are free from infectious diseases. Birds were euthanized in the animal facility using CO₂ and subjected to necropsy according to a standard protocol. All animal procedures complied with the ethical standards set by European Convention ETS No. 123.
The ceca were isolated by applying ligatures at the junction with the rectum, excised, placed in separate containers and transported to the laboratory under a cold chain (2–8 °C). Within maximum 30 minutes of obtaining the isolated ceca, the contents of each were extruded into sterile disposable dishes and labeled. The resulting aliquots of each chyme sample were diluted 1:100 with buffered peptone water and resuspended by vigorous mixing to obtain a homogeneous suspension.
To isolate spore-forming bacteria, the aliquots were heated in a water bath at 65 °C for 45 minutes [46].
To obtain isolated colonies, the heated aliquots were streaked onto Tryptic Soy Agar (SCD agar; HiMedia Laboratories Pvt Ltd., India). Cultivation was carried out under aerobic conditions at (37 ± 1) °C. The cultures were examined after 18, 24, and 36 hours of incubation.
Colonies exhibiting morphological characteristics of the Bacillus genus were selected and purified by repeated streaking on SCD agar. After 18 and 24 hours of cultivation, following visual assessment of growth and microscopy of gram-stained smears, isolates of spore-forming bacteria were subcultured into Tryptic Soy Broth (TSB; SCD broth; HiMedia Laboratories Pvt Ltd., India), and broth cultures of vegetative cells were used for further work.
Phenotypic characterization. A phenotypic characterization of the spore-forming bacterial isolates was performed based on morphological properties, Gram staining,hemolytic activity, catalase activity, biofilm-forming capacity and antibiotic susceptibility. All tests were performed in duplicate.
Isolate identification. Phenotypic identification of the spore-forming bacterial isolates was conducted using commercial disposable biochemical diagnostic test panels API 50CHB (bioMérieux, France). This test classifies bacterial strains based on their ability to ferment 49 different carbohydrates. Results were analyzed using the APIWEB™ software (bioMérieux, France).
Hemolytic activity test. The hemolytic properties of the spore-forming bacterial isolates were determined using Columbia agar (HiMedia Laboratories Pvt Ltd., India) supplemented with 5% sterile defibrinated sheep blood. Twenty-four-hour cultures of the isolates were stab-inoculated onto the agar surface. The reaction was recorded 24 hours after incubation at (37 ± 1) °C. An isolate was considered α-hemolytic if colonies caused a green or brown discoloration of the surrounding medium, β-hemolytic if true lysis of erythrocytes resulted in a clear, transparent zone surrounding the colonies, and γ-hemolytic (non-hemolytic) if no reaction was observed in the surrounding medium [47].
Catalase test. The catalase activity of bacterial isolates was determined using a 10% hydrogen peroxide solution [48]. The liberation of oxygen, evident by the formation of gas bubbles, indicated catalase production.
Antibiotic susceptibility test. The antibiotic susceptibility of Bacillus sp. isolates was tested using the disk diffusion method [49]. Standard antibiotic-impregnated discs (HiMedia Laboratories Pvt Ltd., India) with the following concentrations (5 to 30 μg/disk) were used: ciprofloxacin (Cip 5), rifampicin (Rif 5), enrofloxacin (Ex5), doxycycline (Do10), gentamicin (Gen10), neomycin (N30), cefazolin (Cz30), norfloxacin (Nx10), benzylpenicillin (P100), pefloxacin (Pf5), kanamycin (K30), lincomycin (L15), azithromycin (AZM15), nalidixic acid (NA30), chloramphenicol (C30), oxytetracycline (O30), imipenem (Ipm10), oleandomycin (Ol15), clindamycin (Cd2), clarithromycin (Clr15), oxacillin (Ox1), ampicillin (Amp25).
Eighteen-hour agar cultures of spore-forming bacteria were adjusted to a 0.5 McFarland standard; 250 μL of the culture was swabbed onto the surface of SCD agar plates, and antibiotic discs were dispensed (8 per plate) using a dispenser (HiMedia Laboratories Pvt Ltd., India). Plates were then incubated at (37 ± 1) °C for 20–24 hours.
Strains were classified as resistant (R) if the inhibition zone diameters for the antibiotics listed in EFSA (European Food Safety Authority) documents exceeded the threshold level for Bacillus strains [50]. For antibiotics lacking reliable interpretive criteria, Bacillus strains exhibiting inhibition zones of less than 12 mm around the antibiotic disc were considered resistant.
Determination of biofilm producers. Screening of spore-forming bacteria as potential biofilm producers was performed using a qualitative method by detecting extracellular amyloid proteins on Brain Heart Infusion Agar (BHI agar; HiMedia Laboratories Pvt Ltd., India) supplemented with Congo red indicator and 5% sucrose [31].
A 24-hour broth culture of the test isolate was stabinoculated onto Congo red BHI agar and incubated for 48 hours at (37 ± 1) °C. The color and morphology of the resulting colonies were assessed visually.
The interaction of Congo red with amyloid proteins of the biofilm produces a compound that gives colonies a dark red or dark brown color with a black base. Weak biofilm producers typically remain pink, though some darkening in the center may be observed. Isolates incapable of forming biofilms produce white or very light pink colonies [51].
RESULTS AND DISCUSSION
During the study, a total of 68 strains of aerobic spore-forming bacteria of the genus Bacillus were isolated and identified to the species level.
Phenotypic data confirmed that the isolates obtained from the contents of the ceca of the large intestine of clinically healthy birds belonged to spore-forming bacteria.
The identified isolates of spore-forming bacteria were represented by 5 species: Bacillus licheniformis, Bacillus subtilis/amyloliquefaciens, Bacillus megaterium, Bacillus cereus and Bacillus mucoides. A number of isolates could not be identified using the standardized API 50CHB system.
Microscopic examination of the isolated cells revealed a diverse collection of rod-shaped bacteria producing endospores of various sizes and shapes.
The colonies of spore-forming bacteria exhibited significant polymorphism. B. licheniformis isolates, after 18–24 hours of growth on SCD agar, formed raised, medium-sized colonies colored white or beige, with a flower-like shape.
When cultured on SCD agar, B. subtilis/amyloliquefaciens isolates grew into large white, medium-sized colonies with a lighter central point, or rough undulating colonies of a white-cream color with a dry, finely wrinkled structure, slightly raised above the agar surface.
Bacillus megaterium isolates on SCD agar formed sharply defined colonies of a dirty white color.
Morphologically, the colonies of B. mucoides and B. cereus isolates were identical and appeared as rough, spreading, rhizoid, greyish-white colonies with undulating edges, or as wrinkled, milky-colored colonies with wavy edges.
The isolated spore-forming bacteria were assessed for their safety based on hemolytic activity (Table 1).
Table 1
Hemolytic activity and biofilm-forming capacity of spore-forming bacterial isolates from poultry cecal appendages
| 
 Isolate species identification using the standardized API 50CHB system  | 
 Total number of isolates  | 
 Number of hemolytically active isolates  | 
 Number of isolates – potential biofilm producers  | 
||
| 
 Type of hemolysis  | 
|||||
| 
 α  | 
 β  | 
 γ  | 
|||
| 
 B. licheniformis  | 
 26  | 
 0  | 
 4  | 
 6  | 
 23  | 
| 
 B. subtilis/amyloliquefaciens  | 
 16  | 
 0  | 
 3  | 
 1  | 
 16  | 
| 
 B. megaterium  | 
 3  | 
 0  | 
 2  | 
 1  | 
 2  | 
| 
 B. mycoides  | 
 5  | 
 0  | 
 0  | 
 0  | 
 5  | 
| 
 B. cereus  | 
 7  | 
 0  | 
 5  | 
 1  | 
 5  | 
| 
 Unidentified species  | 
 11  | 
 0  | 
 5  | 
 4  | 
 not tested  | 
| 
 Total  | 
 68  | 
 0  | 
 19  | 
 13  | 
 51  | 
All isolates of spore-forming bacteria obtained from the chyme samples of birds’ ceca lacked α-hemolytic activity. Growth on blood agar revealed a wide zone of hemolysis, characteristic of β-hemolytic bacteria, in 14 out of the 57 studied isolates of the species B. licheniformis, B. subtilis/amyloliquefaciens, B. megaterium, and B. cereus (Fig. 1). It was found that 9 isolates of spore-forming bacteria exhibited γ-hemolytic activity.
Fig. 1. Hemolytic activity of Bacillus isolates cultured on sheep blood-supplemented SCD agar at (37 ± 1) °C for 24 hours
The majority of the studied isolates of spore-forming microorganisms grown on Congo red BHI agar were classified as potential biofilm producers based on their dark red colonies with a black base, with the exception of 3 isolates of B. licheniformis, 1 isolate of B. megaterium, and 2 isolates of B. cereus, which formed light pink colonies (Fig. 2).
Fig. 2. Bacillus isolates cultured on Congo red-supplemented BHI agar at (37 ± 1) °C for 24 hours
Antibiotic susceptibility tests showed that the majority of the studied isolates of spore-forming bacteria were sensitive to all 22 antibiotics tested (Table 2).
Table 2
Antibiotic sensitivity profiles of 57 spore-forming isolates determined using disk diffusion method
| 
 № п/п  | 
 Antibiotic disc type  | 
 Number of antibiotic-sensitive isolates  | 
||||
| 
 B. licheniformis (n = 26)  | 
 B. subtilis/ amyloliquefaciens (n = 16)  | 
 B. megaterium (n = 3)  | 
 B. mycoides (n = 5)  | 
 B. cereus (n = 7)  | 
||
| 
 1  | 
 Ciprofloxacin (5 μg/disk)  | 
 +  | 
 +  | 
 +  | 
 +  | 
 +  | 
| 
 2  | 
 Rifampicin (5 μg/disk)  | 
 2  | 
 1  | 
 1  | 
 +  | 
 +  | 
| 
 3  | 
 Enrofloxacin (5 μg/disk)  | 
 +  | 
 +  | 
 +  | 
 +  | 
 +  | 
| 
 4  | 
 Doxycycline (10 μg/disk)  | 
 +  | 
 +  | 
 +  | 
 +  | 
 +  | 
| 
 5  | 
 Gentamicin (10 μg/disk)  | 
 +  | 
 +  | 
 +  | 
 +  | 
 +  | 
| 
 6  | 
 Neomycin (30 μg/disk)  | 
 +  | 
 +  | 
 +  | 
 +  | 
 +  | 
| 
 7  | 
 Cefazolin (30 μg/disk)  | 
 3  | 
 +  | 
 1  | 
 +  | 
 3  | 
| 
 8  | 
 Norfloxacin (10 μg/disk)  | 
 +  | 
 +  | 
 +  | 
 +  | 
 +  | 
| 
 9  | 
 Benzylpenicillin (100 μg/disk)  | 
 +  | 
 +  | 
 +  | 
 +  | 
 +  | 
| 
 10  | 
 Pefloxacin (5 μg/disk)  | 
 +  | 
 +  | 
 +  | 
 +  | 
 +  | 
| 
 11  | 
 Kanamycin (30 μg/disk)  | 
 +  | 
 +  | 
 +  | 
 1  | 
 +  | 
| 
 12  | 
 Lincomycin (15 μg/disk)  | 
 8  | 
 3  | 
 1  | 
 +  | 
 +  | 
| 
 13  | 
 Azithromycin (15 μg/disk)  | 
 +  | 
 2  | 
 +  | 
 +  | 
 +  | 
| 
 14  | 
 Nalidixic acid (30 μg/disk)  | 
 +  | 
 +  | 
 +  | 
 +  | 
 +  | 
| 
 15  | 
 Chloramphenicol (30 μg/disk)  | 
 +  | 
 +  | 
 +  | 
 +  | 
 +  | 
| 
 16  | 
 Oxytetracycline (30 μg/disk)  | 
 2  | 
 2  | 
 +  | 
 1  | 
 1  | 
| 
 17  | 
 Imipenem (10 μg/disk)  | 
 +  | 
 +  | 
 +  | 
 +  | 
 +  | 
| 
 18  | 
 Oleandomycin (15 μg/disk)  | 
 +  | 
 +  | 
 +  | 
 +  | 
 +  | 
| 
 19  | 
 Ampicillin (25 μg/disk)  | 
 +  | 
 +  | 
 +  | 
 +  | 
 +  | 
| 
 20  | 
 Clindamycin (2 μg/disk)  | 
 +  | 
 +  | 
 +  | 
 +  | 
 +  | 
| 
 21  | 
 Clarithromycin (15 μg/disk)  | 
 +  | 
 +  | 
 +  | 
 +  | 
 +  | 
| 
 22  | 
 Oxacillin (1 μg/disk)  | 
 +  | 
 +  | 
 +  | 
 +  | 
 +  | 
Only 4 isolates of spore-forming bacteria were resistant to rifampicin, 7 – to cefazolin, 12 – to lincomycin, and 6 – to oxytetracycline. Some isolates were resistant to 2 antibiotics, but the majority of isolates exhibited resistance to maximum one antibiotic.
CONCLUSION
Based on the test results, the identified species of spore-forming bacteria of the genus Bacillus isolated from the ceca of commercial poultry included: B. licheniformis, B. subtilis/amyloliquefaciens, B. mycoides, B. megaterium and B. cereus; a number of isolates could not be identified.
All studied isolates were catalase-positive and lacked α-hemolytic activity. Some isolates exhibited β-hemolytic activity, which precludes their classification as non-pathogenic.
The potential ability of the isolated strains to form biofilms, which indirectly characterizes their capacity to survive in the intestine, was additionally investigated. The vast majority of isolates were classified as potential biofilm-forming phenotypes and demonstrated susceptibility to all 22 tested antibiotics.
Hemolytically active intestinal isolates of spore-forming bacteria cannot be considered safe until the effect of this virulence factor on the animal organism is elucidated.
The research results can be used for the selection of candidate strains of bacteria of the genus Bacillus chosen as probiotics.
Contribution of the authors: Malik N. I. – scientific supervision, research implementation, methodology, formal analysis, manuscript writing; Chupahina N. A. and Rusanov I. A. – investigation, formal analysis and data processing, table preparation, digital image preparation; Malik E. V. – formal analysis, data processing, article manuscript preparation; Malenkova L. A. and Samokhvalova N. S. – literature review and analysis; Surogin M. V. – text editing.
Вклад авторов: Малик Н. И. – научное руководство, проведение исследований, методология, формальный анализ, написание текста статьи; Чупахина Н. А. и Русанов И. А. – исследование, формальный анализ и обработка данных, составление таблиц, подготовка цифровых снимков; Малик Е. В. – формальный анализ, обработка данных, подготовка текста статьи; Маленкова Л. А. и Самохвалова Н. С. – подбор и анализ литературных источников по теме; Сурогин М. В. – редактирование текста.
References
1. Von Martels J. Z., Sadabad M. S., Bourgonje A. R., Blokzijl T., Dijkstra G., Faber K. N., Harmsen H. J. M. The role of gut microbiota in health and disease: in vitro modeling of host-microbe interactions at the aerobe-anaerobe interphase of the human gut. Anaerobe. 2017; 44: 3–12. https://doi.org/10.1016/j.anaerobe.2017.01.001
2. Kearney S. M., Gibbons S. M., Poyet M., Gurry T., Bullock K., Allegretti J. R., et al. Endospores and other lysis-resistant bacteria comprise a widely shared core community within the human microbiota. The ISME Journal. 2018; 12 (10): 2403–2416. https://doi.org/10.1038/s41396-018-0192-z
3. Lan P. T. N., Hayashi H., Sakamoto M., Benno Y. Phylogenetic analysis of cecal microbiota in chicken by the use of 16S rDNA clone libraries. Microbiology and Immunology. 2002; 46 (6): 371–382. https://doi.org/10.1111/j.1348-0421.2002.tb02709.x
4. Tetz G, Tetz V. Introducing the sporobiota and sporobiome. Gut Pathogens. 2017; 9 (1):38. https://doi:10.1186/s13099-017-0187-8
5. Elshaghabee F. M., Rokana N., Gulhane R. D., Sharma C., Panwar H. Bacillus as potential probiotics: status, concerns, and future perspectives. Frontiers in Microbiology. 2017; 8:1490. https://doi.org/10.3389/fmicb.2017.01490
6. Egan M., Dempsey E., Ryan C. A., Ross R. P., Stanton C. The sporobiota of the human gut. Gut Microbes. 2021; 13 (1):е1863134. https://doi.org/10.1080/19490976.2020.1863134
7. Zeigler D. R., Perkins J. B. The Genus Bacillus. In: Practical Handbook of Microbiology. Ed. by L. H. Green, E. Goldman. 4th ed. Boca Raton: CRC Press; 2021; Chapter 22: 249–278. https://doi.org/10.1201/9781003099277
8. Priest F. G. Systematics and Ecology of Bacillus. In: Bacillus subtilis and Other Gram-Positive Bacteria: Biochemistry, Physiology, and Molecular Genetics. Ed. by A. L. Sonenshein, J. A. Hoch, R. Losick. Washington: American Society for Microbiology; 1993; Chapter 1: 1–16. https://doi.org/10.1128/9781555818388.ch1
9. Barbosa T. M., Serra C. R., La Ragione R. M., Woodward M. J., Henriques A. O. Screening for Bacillus isolates in the broiler gastrointestinal tract. Applied and Environmental Microbiology. 2005; 71 (2): 968–978. https://doi.org/10.1128/AEM.71.2.968-978.2005
10. Hoa T. T., Duc L. H., Isticato R., Baccigalupi L., Ricca E., Van P. H., Cutting S. M. Fate and dissemination of Bacillus subtilis spores in a murine model. Applied and Environmental Microbiology. 2001; 67 (9): 3819–3823. https://doi.org/10.1128/AEM.67.9.3819-3823.2001
11. Mohammed A. A., Zaki R. S., Negm E. A., Mahmoud M. A., Cheng H. W. Effects of dietary supplementation of a probiotic (Bacillus subtilis) on bone mass and meat quality of broiler chickens. Poultry Science. 2021; 100 (3):100906. https://doi.org/10.1016/j.psj.2020.11.073
12. Abramowicz K., Krauze M., Ognik K. The effect of a probiotic preparation containing Bacillus subtilis PB6 in the diet of chickens on redox and biochemical parameters in their blood. Annals of Animal Science. 2019; 19 (2): 433–451. https://doi.org/10.2478/aoas-2018-0059
13. Lelyak A. A., Shternshis M. V. Antagonistic potential of Siberian strains of Bacillus spp. towards agents causing animal and plant diseases. Tomsk State University Journal of Biology. 2014; (1): 42–55. https://elibrary.ru/tgwlvz (in Russ.)
14. Dong Y., Li R., Liu Y., Ma L., Zha J., Qiao X., et al. Benefit of dietary supplementation with Bacillus subtilis BYS2 on growth performance, immune response, and disease resistance of broilers. Probiotics and Antimicrobial Proteins. 2020; 12: 1385–1397. https://doi.org/10.1007/s12602-020-09643-w
15. SmirnovV. V., Reznik S. R., Kudriavtsev V. A., Osadchaia A. I., Safronova L. A. Extracellular amino acids of aerobic spore-forming bacteria. Mikrobiologiia. 1992; 61 (5): 865–872. https://pubmed.ncbi.nlm.nih.gov/1287408 (in Russ.)
16. Wu B. Q., Zhang T., Guo L. Q., Lin J. F. Effects of Bacillus subtilis KD1 on broiler intestinal flora. Poultry Science. 2011; 90 (11): 2493–2499. https://doi.org/10.3382/ps.2011-01529
17. Sumi C. D., Yang B. W., Yeo I.-C., Hahm Y. T. Antimicrobial peptides of the genus Bacillus: a new era for antibiotics. Canadian Journal of Microbiology. 2015; 61 (2): 93–103. https://doi.org/10.1139/cjm-2014-0613
18. Horosheva T. V., Vodyanoy V., Sorokulova I. Efficacy of Bacillus probiotics in prevention of antibiotic‐associated diarrhoea: a randomized, double‐blind, placebo‐controlled clinical trial. JMM Case Reports. 2014; 1 (3):e004036. https://doi.org/10.1099/jmmcr.0.004036
19. Sorokulova I. Modern status and perspectives of Bacillus bacteria as probiotics. Journal of Probiotics & Health. 2013; 1 (4):е106. https://doi.org/10.4172/2329-8901.1000e106
20. Duc L. H., Hong H. A., Uyen N. Q., Cutting S. M. Intracellular fate and immunogenicity of B. subtilis spores. Vaccine. 2004; 22 (15–16): 1873–1885. https://doi.org/10.1016/j.vaccine.2003.11.021
21. Lu S., Na K., Li Y., Zhang L., Fang Y., Guo X. Bacillus-derived probiotics: metabolites and mechanisms involved in bacteria – host interactions. Critical Reviews in Food Science and Nutrition. 2024; 64 (6): 1701–1714. https://doi.org/10.1080/10408398.2022.2118659
22. Kubota H., Senda S., Nomura N., Tokuda H., Uchiyama H. Biofilm formation by lactic acid bacteria and resistance to environmental stress. Journal of Bioscience and Bioengineering. 2008; 106 (4): 381–386. https://doi.org/10.1263/jbb.106.381
23. Todorov S. D., Ivanova I. V., Popov I., Weeks R., Chikindas M. L. Bacillus spore-forming probiotics: benefits with concerns? Critical Reviews in Microbiology. 2022; 48 (4): 513–530. https://doi.org/10.1080/1040841X.2021.1983517
24. Costerton J. W., Stewart P. S., Greenberg E. P. Bacterial biofilms: a common cause of persistent infections. Science. 1999; 284 (5418): 1318–1322. https://doi.org/10.1126/science.284.5418.1318
25. Branda S. S., Vik Å., Friedman L., Kolter R. Biofilms: the matrix revisited. Trends in Microbiology, 2005; 13 (1): 20–26. https://doi.org/10.1016/j.tim.2004.11.006
26. Lasa I., Penadés J. R. Bap: a family of surface proteins involved in biofilm formation. Research in Microbiology. 2006; 157 (2): 99–107. https://doi.org/10.1016/j.resmic.2005.11.003
27. Taglialegna A., Lasa I., Valle J. Amyloid structures as biofilm matrix scaffolds. Journal of Bacteriology. 2016; 198 (19): 2579–2588. https://doi.org/10.1128/jb.00122-16
28. Akbey Ü., Andreasen M. Functional amyloids from bacterial biofilms – structural properties and interaction partners. Chemical Science. 2022; 13 (22): 6457–6477. https://doi.org/10.1039/D2SC00645F
29. Cámara-Almirón J. Structural and functional study of bacterial amyloids in Bacillus subtilis: Author’s thesis. Universidad de Málaga; 2020. https://hdl.handle.net/10630/19863
30. Fazeli-Nasab B., Sayyed R. Z., Mojahed L. S., Rahmani A. F., Ghafari M., Antonius S., Sukamto. Biofilm production: a strategic mechanism for survival of microbes under stress conditions. Biocatalysis and Agricultural Biotechnology. 2022; 42:102337. https://doi.org/10.1016/j.bcab.2022.102337
31. Freeman D. J., Falkiner F. R., Keane C. T. New method for detecting slime production by coagulase negative staphylococci. Journal of Clinical Pathology. 1989; 42 (8): 872–874. https://doi.org/10.1136/jcp.42.8.872
32. Saxena N., Maheshwari D., Dadhich D., Singh S. Evaluation of Congo red agar for detection of biofilm production by various clinical Candida isolates. Journal of Evolution of Medical and Dental Sciences. 2014; 3 (59): 13234–13238. https://doi.org/10.14260/jemds/2014/3761
33. Branda S. S., Chu F., Kearns D. B., Losick R., Kolter R. A major protein component of the Bacillus subtilis biofilm matrix. Molecular Microbiology. 2006; 59 (4): 1229–1238. https://doi.org/10.1111/j.1365-2958.2005.05020.x
34. Romero D., Aguilar C., Losick R., Kolter R. Amyloid fibers provide structural integrity to Bacillus subtilis biofilms. Proceedings of the National Academy of Sciences. 2010; 107 (5): 2230–2234. https://doi.org/10.1073/pnas.0910560107
35. Lindsay D., Brözel V. S., Von Holy A. Spore formation in Bacillus subtilis biofilms. Journal of Food Protection. 2005; 68 (4): 860–865. https://doi.org/10.4315/0362-028X-68.4.860
36. Bengtsson-Palme J., Abramova A., Berendonk T. U., Coelho L. P., Forslund S. K., Gschwind R., et al. Towards monitoring of antimicrobial resistance in the environment: For what reasons, how to implement it, and what are the data needs? Environment International. 2023; 178: 108089. https://doi.org/10.1016/j.envint.2023.108089
37. Dulya O., Mikryukov V., Shchepkin D. V., Pent M., Tamm H., Guazzini M., et al. A trait-based ecological perspective on the soil microbial antibiotic-related genetic machinery. Environment International. 2024; 190:108917. https://doi.org/10.1016/j.envint.2024.108917
38. BerićT., Biočanin M., Stanković S., Dimkić I., Janakiev T., Fira Đ., Lozo J. Identification and antibiotic resistance of Bacillus spp. isolates from natural samples. Archives of Biological Sciences. 2018; 70 (3): 581–588. https://doi.org/10.2298/ABS180302019B
39. Adamski P., Byczkowska-Rostkowska Z., Gajewska J., Zakrzewski A. J., Kłębukowska L. Prevalence and antibiotic resistance of Bacillus sp. isolated from raw milk. Microorganisms. 2023; 11 (4):1065. https://doi.org/10.3390/microorganisms11041065
40. Kowalska J., Maćkiw E., Stasiak M., Kucharek K., Postupolski J. Biofilm-forming ability of pathogenic bacteria isolated from retail food in Poland. Journal of Food Protection. 2020; 83 (12): 2032–2040. https://doi.org/10.4315/JFP-20-135
41. Morikawa M. Beneficial biofilm formation by industrial bacteria Bacillus subtilis and related species. Journal of Bioscience and Bioengineering. 2006; 101 (1): 1–8. https://doi.org/10.1263/jbb.101.1
42. Bernheimer A. W., Avigad L. S. Nature and properties of a cytolytic agent produced by Bacillus subtilis. Microbiology. 1970; 61 (3): 361–369. https://doi.org/10.1099/00221287-61-3-361
43. AlGburi A., Volski A., Cugini C., Walsh E. М., Chistyakov V. А., Mazanko M. S., et al. Safety properties and probiotic potential of Bacillus subtilis KATMIRA1933 and Bacillus amyloliquefaciens B-1895. Advances in Microbiology. 2016; 6 (6): 432–452. https://doi.org/10.4236/aim.2016.66043
44. Deng F., Chen Y., Sun T., Wu Y., Su Y., Liu C., et al. Antimicrobial resistance, virulence characteristics and genotypes of Bacillus spp. from probiotic products of diverse origins. Food Research International. 2021; 139:109949. https://doi.org/10.1016/j.foodres.2020.109949
45. Pokhilenko V. D., Perelygin V. V. Probiotics on the basis of spore-forming bacteria and their safety. Chemical and Biological Safety. 2007; (2–3): 20–41. https://www.cbsafety.ru/rus/saf_32_2.asp (in Russ.)
46. Otiniano N. M., Farfán-Córdova M., Cabeza J. G., Cabanillas-Chirinos L. Isolation and selection of spore-forming bacilli with potential for self-healing of concrete. Scientific Reports. 2024; 14:27223. https://doi.org/10.1038/s41598-024-77241-9
47. Buxton R. Blood agar plates and hemolysis protocols. American Society for Microbiology. 30 September 2005. 9 p. https://asm.org/getattachment/7ec0de2b-bb16-4f6e-ba07-2aea25a43e76/protocol
48. General Pharmacopoeia Monograph GPM.1.7.2.0012.15. Production probiotic strains and strains for probiotic control. The State Pharmacopoeia of the Russian Federation. XIV ed. https://pharmacopoeia.regmed.ru/pharmacopoeia/izdanie-14/1/1-7/1-7-2/proizvodstvennye-probioticheskie-shtammy-i-shtammy-dlya-kontrolya-probiotikov (in Russ.)
49. Determination of the sensitivity of microorganisms to antimicrobial agents: recommendations of the Interregional Association for Clinical Microbiology and Antimicrobial Chemotherapy. Version 2021-01. https://www.antibiotic.ru/files/321/clrec-dsma2021.pdf (in Russ.)
50. EFSA Panel on Additives and Products or Substances used in Animal Feed (FEEDAP). Guidance on the assessment of bacterial susceptibility to antimicrobials of human and veterinary importance. EFSA Journal. 2012; 10 (6):2740. https://doi.org/10.2903/j.efsa.2012.2740
51. Okouakoua F. Y., Kayath C. A., Mokemiabeka S. N., Moukala D. C. R., Kaya-Ongoto M. D., Nguimbi E. Involvement of the Bacillus SecYEG pathway in biosurfactant production and biofilm formation. International Journal of Microbiology. 2024; 2024:6627190. https://doi.org/10.1155/2024/6627190
About the Authors
N. I. MalikRussian Federation
Nina I. Malik - Dr. Sci. (Biology), Professor, Chief Researcher, Department of Scientific Planning and Research, The Russian State Centеr for Quality and Standardization of Veterinary Drugs and Feed.
5 Zvenigorodskoe shosse, Moscow 123022
N. A. Chupahina
Russian Federation
Nataliya A. Chupahina - Cand. Sci. (Biology), Leading Researcher, Department of Bacteriology, The Russian State Centеr for Quality and Standardization of Veterinary Drugs and Feed.
5 Zvenigorodskoe shosse, Moscow 123022
I. A. Rusanov
Russian Federation
Ivan A. Rusanov - Senior Researcher, Scientific and Technological Laboratory, The Russian State Centеr for Quality and Standardization of Veterinary Drugs and Feed.
5 Zvenigorodskoe shosse, Moscow 123022
E. V. Malik
Russian Federation
Evgeniy V. Malik - Cand. Sci. (Veterinary Medicine), Leading Researcher, Department of Scientific Planning and Research, The Russian State Centеr for Quality and Standardization of Veterinary Drugs and Feed.
5 Zvenigorodskoe shosse, Moscow 123022
L. A. Malenkova
Russian Federation
Liya A. Malenkova - Senior Researcher, Department of Bacteriology, The Russian State Centеr for Quality and Standardization of Veterinary Drugs and Feed.
5 Zvenigorodskoe shosse, Moscow 123022
N. S. Samokhvalova
Russian Federation
Nadezhda S. Samokhvalova - Researcher, Department of Bacteriology, The Russian State Centеr for Quality and Standardization of Veterinary Drugs and Feed.
5 Zvenigorodskoe shosse, Moscow 123022
M. V. Surogin
Russian Federation
Mikhail V. Surogin - Cand. Sci. (Veterinary Medicine), Head of Department of Bacteriology, The Russian State Centеr for Quality and Standardization of Veterinary Drugs and Feed.
5 Zvenigorodskoe shosse, Moscow 123022
Review
For citations:
Malik N.I., Chupahina N.A., Rusanov I.A., Malik E.V., Malenkova L.A., Samokhvalova N.S., Surogin M.V. Identification and some biological characteristics of Bacillus strains isolated from poultry large intestine. Veterinary Science Today. 2025;14(3):302-309. https://doi.org/10.29326/2304-196X-2025-14-3-302-309
                    
        
            

























